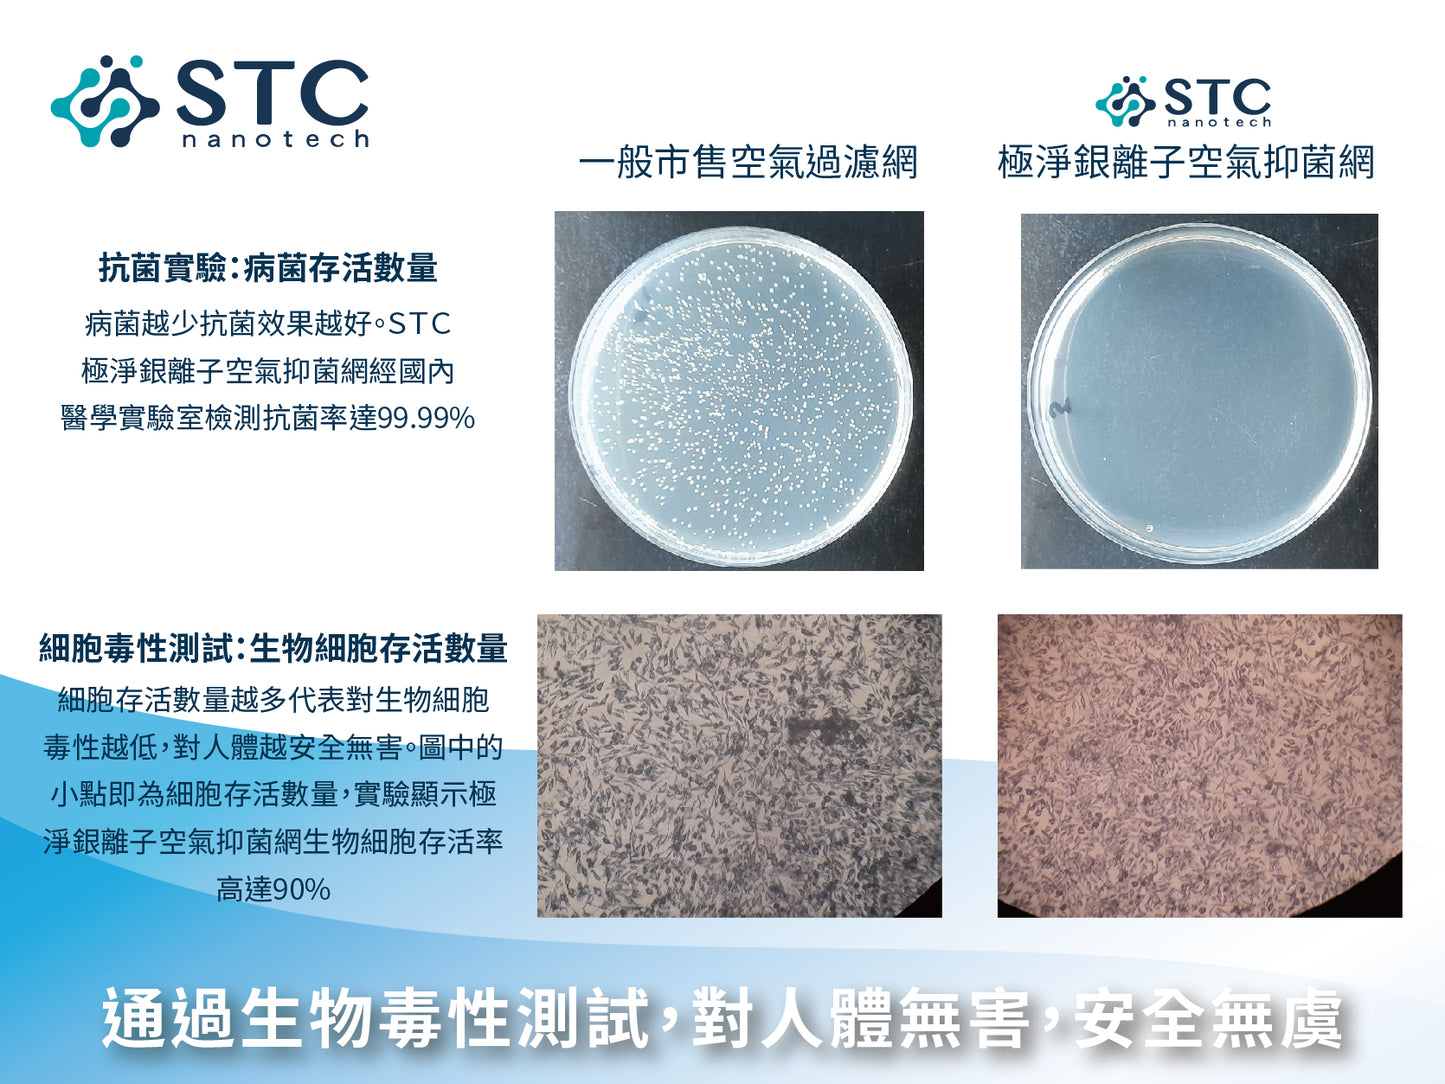

stcnanotech
極淨銀離子空氣抑菌網-花小錢省大錢減少空調昂貴的清洗費用及頻率
極淨銀離子空氣抑菌網-花小錢省大錢減少空調昂貴的清洗費用及頻率
定價
$790.00 TWD
定價
售價
$790.00 TWD
單價
每
無法載入取貨服務供應情況
極淨銀離子空氣抑菌網-花小錢省大錢減少空調昂貴的清洗費用及頻率
特色說明 Features
使用方法&注意事項 Directions for Use
1.參照欲安裝之冷氣機或空氣清淨機濾網大小,將空氣抑菌網剪裁至相同大小。
2.將空氣抑菌網銀色面朝外貼附在原廠濾網後一起安裝至機器中。
3.銀離子空氣抑菌網務必安裝在進風處。
保存期限及方法:
未開封3年,開封後一年。保存在乾燥陰涼處。建議:6~8個月更換一次,或抑菌網大面積變色後即可更換。
產品規格 Product Specifications
材質Material:聚丙烯Polypropylene
規格Dimensions:寬:25cm * 長:6m
淨重Net weight:172.5g
產地Place of Manufacture:台灣 Taiwan
SGS檢測菌種抑菌率SGS tested antimicrobial effectiveness:
金黃色葡萄球菌>99.9%(UG/2020/21087A-02)Staphylococcus aureus >99.9%
大腸桿菌 99.6%(UG/2020/21088A-02)E. coli 99.6%
肺炎鏈球菌 >99.9%(UG/2020/21089A-02)Streptococcus pneumoniae>99.9%
綠膿桿菌>99.9%(UG/2020/21090A-02)Pseudomonas aeruginosa>99.9%
白色念珠菌 99.6%(UG/2020/21091A-02)Candida albicans 99.6%
黑麴菌 94.7%(UG/2020/21092A-02)Aspergillus brasiliensis 94.7%